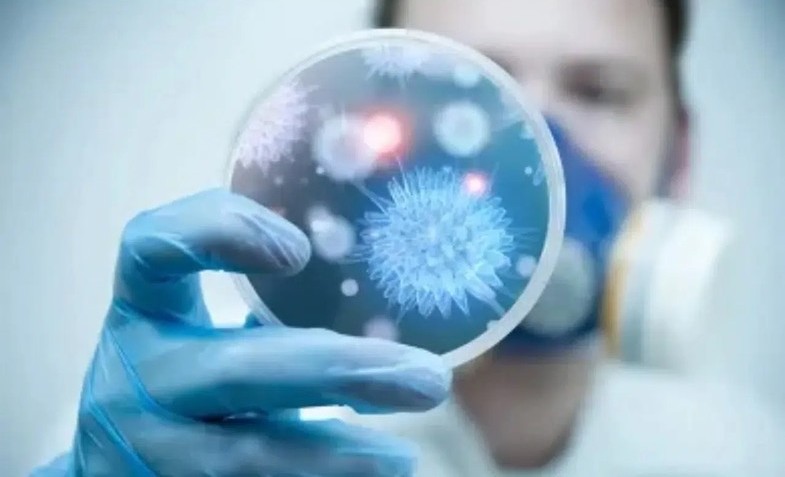

Frankenstein Varyantı Nedir? COVID-19’un Yeni Türü Belirtileri ve Tedavisi
Frankenstein varyantı nedir? COVID-19’un yeni türü belirtileri ve tedavi yöntemleri hakkında detaylı bilgi.
COVID-19 pandemisi boyunca virüslerde yaşanan değişimler, sağlık otoritelerinin ve bilim insanlarının sürekli gündeminde olmaya devam ediyor. Virüsün evrimi, yeni varyantların ortaya çıkmasıyla birlikte ister hafif seyretsin ister ciddi sağlık problemlerine yol açsın, toplumu yakından ilgilendiren önemli bir konu olmayı sürdürüyor. Son dönemde ise adını sıkça duyduğumuz Frankenstein varyantı, virüsün genetik yapısında meydana gelen melezleşme ve yeni özellikler kazanmasıyla gündeme geldi. Bu varyant, özellikle bulaşma hızındaki artış ve belirtilerdeki farklılıklarla dikkati çekiyor. Ancak, bu yeni nesil varyantın virüsün evrimine katkıları ve toplumsal etkileri konusunda detaylı bilgilere önemle ihtiyaç duyuluyor.
Bu içeriğimizde, Frankenstein varyantının bilimsel özelliklerinden, belirtilerine, bulaşma yollarından tedavi ve önleme yöntemlerine kadar geniş bir perspektifle ele alıyoruz. Ayrıca, mevcut aşıların ve antivirallerin bu varyanta karşı etkisi ve olası güçlendirme stratejileri üzerine de detaylı bilgiler sunuyoruz. Amacımız, hem halkın bilinçlenmesine katkıda bulunmak hem de sağlık profesyonellerinin ve ilgilenenlerin güncel bilgiler ışığında doğru kararlar alabilmesine yardımcı olmaktır. Bilimsel verilere dayanan bu detaylı değerlendirmeyle, pandemiyle mücadelede daha bilinçli ve etkili adımlar atabilmek oldukça kritik önemdedir.
Frankenstein Varyantının Genetik ve Bilimsel Özellikleri
Virüsün yeni melez yapısı, iki ya da daha fazla farklı varyantın genetik materyallerinin birleşmesiyle oluşuyor. Normalde, SARS-CoV-2 virüsü genellikle tek bir varyant şeklinde dolaşırken, Frankenstein varyantı, özellikle Omicron’un birkaç alt varyantının aynı enfeksiyonda birleşip yeni bir genetik profil oluşturması sonucu ortaya çıkıyor. Bu durum, virüsün yeni bağışıklık yanıtlardan kaçma kabiliyetini paralel olarak artırırken, bulaşma hızını da yükseltiyor. Ayrıca, virusun farklı yapıların kombinasyonu, o bölgedeki enfekte kişilerin vücutlarında farklı belirtilerin ortaya çıkmasına neden oluyor. Bununla birlikte, laboratuvar çalışmalarında, Frankenstein varyantının hücrelere giriş ve çoğalma hızı, önceki varyantlara kıyasla biraz daha yüksek bulunuyor. Bu, virüsün mutasyonlarıyla birlikte daha hızlı yayılabilmesine olanak tanıyor.
Genetik yapısına bakıldığında,Spike proteini bölgelerinde birkaç yeni mutasyon saptanmış durumda. Bu mutasyonlar, virüsün insan hücrelerine bağlanma kabiliyetini etkiliyor. Ayrıca, bağışıklık sistemi tarafından tanınma oranını azaltarak, aşılara karşı kısmi direnç geliştirebiliyor. Melez yapısı nedeniyle, farklı bağışıklık yanıtlarına karşı değişik seviyelerde etkili olabiliyor. Bu nedenle, Frankenstein varyantı, hem klinik hem de laboratuvar çalışmalarında özel dikkat gerektiren bir alt gruba yerleştiriliyor.
Varyantın Klinik Belirtileri ve Semptomların Evrimi
Klasik COVID-19 enfeksiyonlarında görülen semptomlara ek olarak, Frankenstein varyantı bazı özgün belirtilerle kendini gösteriyor. En dikkat çekici olanı, boğazda bıçak saplanmış gibi keskin ve ani başlayan ağrı. Ses kısıklığı ve yutkunma zorluğu bu varyantta oldukça sık rastlanan semptomlar arasında. Bu özellikler, virüsün solunum yollarını etkili şekilde hedef almasını gösteriyor. Diğer yandan, yüksek ateş ve halsizlik gibi klasik belirtiler de yoğunluk gösterebiliyor. Öksürük, özellikle kuru öksürük şeklinde, hem virüsün solunum sistemine verdiği zararın hem de enfekte kişide oluşan iltihap reaksiyonlarının bir sonucu olarak ortaya çıkıyor. Ayrıca, bazı vakalarda baş ağrısı, kas ve eklem ağrıları, mide bulantısı ve şiddetli yorgunluk semptomları da gözlemleniyor.

Bununla birlikte, özellikle risk grubundakilerde, ağır solunum yolu enfeksiyonu ve nefes darlığı gibi ciddi semptomlar da görülebiliyor. Bu noktada, enfeksiyonun süresi ve gelişim hızının, kişinin bağışıklık sistemi ve virüsün genetik yapısına göre değişiklik gösterdiğini eklemek önemli. Semptomların genellikle 3 ile 5 gün arası zirve yaptığı ve iyileşmenin ise 1 ila 2 hafta arasında değiştiği gözlemleniyor. Dolayısıyla, özellikle risk altındaki bireylerin, ilk belirtiler ortaya çıkar çıkmaz ilgili sağlık kuruluşlarına başvurması ve uyumlu tedavi planı uygulaması büyük önem taşıyor.
Bulaşma Yöntemleri ve Salgın Kontrolü
Yeni varyantın özellikle bulaşma hızı yüksek olduğu için, covid önlemlerinde yeni yaklaşımlar ve daha dikkatli davranışlar gerekebiliyor. Temel koruyucu yöntemler aynen devam ediyor: maske takmak, sosyal mesafeye dikkat etmek, hijyen kurallarına uyum sağlamak. Ancak, Frankenstein varyantı, yüksek mutasyon oranı ve melez yapısı nedeniyle, yine de bazı risk faktörleri taşıyor. Bulaşma genellikle solunum damlacıkları ile gerçekleşiyor ve yakın temasta bulunan kişiler arasında hızla yayılıyor. Kapalı, kalabalık ve havasız ortamlarda virüsün yayılımı artıyor. Ayrıca, virüs yüzeylerde kısa süre kalabiliyor, fakat virüsün yüzeyler üzerinden bulaşma oranı, solunum yoluyla bulaşa nazaran oldukça düşük seviyelerde kalmış durumda.
Bu noktada özellikle, aşılı kişilerin koruma oranı, yapılan çalışmalarla destekleniyor. Aşılar, enfeksiyon riskini önemli ölçüde azaltırken, virüsün hafif seyretmesine katkıda bulunuyor. Ancak, yeni varyantlarda belirli aşılara karşı bağışıklıkta zayıflama olabileceği dikkate alınmalı. Bu nedenle, güncel aşı takvimi ve güçlendirme dozu uygulamalarına titizlikle devam edilmesi gerekebilir. Ayrıca, enfekte olan bireylerin izolasyonu ve temas önleme çalışmalarına uyulması, virüsün yayılmasını engellemek adına kritik önemdedir.
Gelişmiş Tanı ve Güvenilir Teşhis Yöntemleri
Mevcut PCR testleri, Frankenstein varyantının tespiti için en gelişmiş ve güvenilir yöntemler arasında yer alıyor. PCR testleri, virüsün genetik materyalini tespit ederek %99’a varan doğrulukla pozitif ya da negatif sonuç veriyor. Test sonucu pozitif çıkarsa, laboratuvar ortamında yapılan genetik dizileme çalışmalarıyla, varyantın belirlenmesi sağlanabiliyor. Bu, varyantın mutasyon profili ve genetik yapısına ilişkin detaylı bilgi sunuyor, ve olası yeni değişikliklerin takip edilmesine olanak tanıyor. Antijen testleri ise daha hızlı sonuç veriyor, fakat değişen varyantların tespit edilmesinde yöntem zayıf kalabiliyor. Bu nedenle, özellikle semptomlar baş gösterdiğinde, kesin tanı için PCR testlerinin tercih edilmesi öneriliyor.
Erken teşhis, enfekte kişilerin izolasyonu ve tedavi sürecinin başlaması açısından büyük önem taşıyor. Ayrıca, toplumu ilgilendiren araştırmalar ve genetik takip programlarıyla, virüsün yeni mutasyonları ve varyantlarının yayılması sürekli izleniyor. Bu sayede, sağlık politikaları ve aşılama stratejileri de güncel tutuluyor.
Yararlanılan Tedavi Seçenekleri ve Güncel Yaklaşımlar
Frankenstein varyantına özel geliştirilmiş bir ilaç veya tedavi protokolü şu an bulunmamaktadır. Ancak, genel COVID-19 tedavi yöntemleri ve antiviral ilaçlar, bu yeni varyantta da etki gösteriyor. Hastanın durumuna göre bağışıklık sistemini destekleyici ilaçlar, hafif ve orta şiddetteki vaka tedavisinde kullanılıyor. En yaygın kullanılanlar arasında Paxlovid gibi ivermektin dışındaki antiviral ilaçlar bulunuyor. Bol sıvı alımı ve istirahat, hastalığın ilerlemesini engellemede temel yordamlar arasında yer alıyor. Ayrıca, yüksek ateş ve ağrı gibi şikayetler için doktorun önerdiği ağrı kesiciler kullanılabiliyor.
Özellikle risk grubu olan bireyler ve yoğun enfekte olan kişiler için, hastaneye yatış gerekebilir. Bu durumda, oksijen desteği ve gerekirse monoklonal antikor tedavileri devreye sokuluyor. Günümüzde, aşıların güçlendirilmiş dozları da, bağışıklık yanıtını artırmak ve hastalığın ağır seyretmesini önlemek amacıyla önerilmektedir. Hasta yakını ve sağlık çalışanları için, hijyen ve izolasyon kurallarına sıkı uyum, yeni varyantların yayılmasını engellemekte en etkili yoldur.
Frankenstein varyantının gelişimi ve yayılımı, salgın yönetiminde yeni riskleri ve önlemleri gündeme getiriyor. Güncel bilimsel araştırmalar ve sağlık otoritelerinin rehberliğinde alınan önlemler, pandeminin kontrol altında tutulmasında kritik role sahip. Bu nedenle, toplumun her kesiminin, aşı ve tedavi uygulamalarına uyum göstererek, pandemi mücadelesinde aktif rol alması büyük önem taşımaktadır.